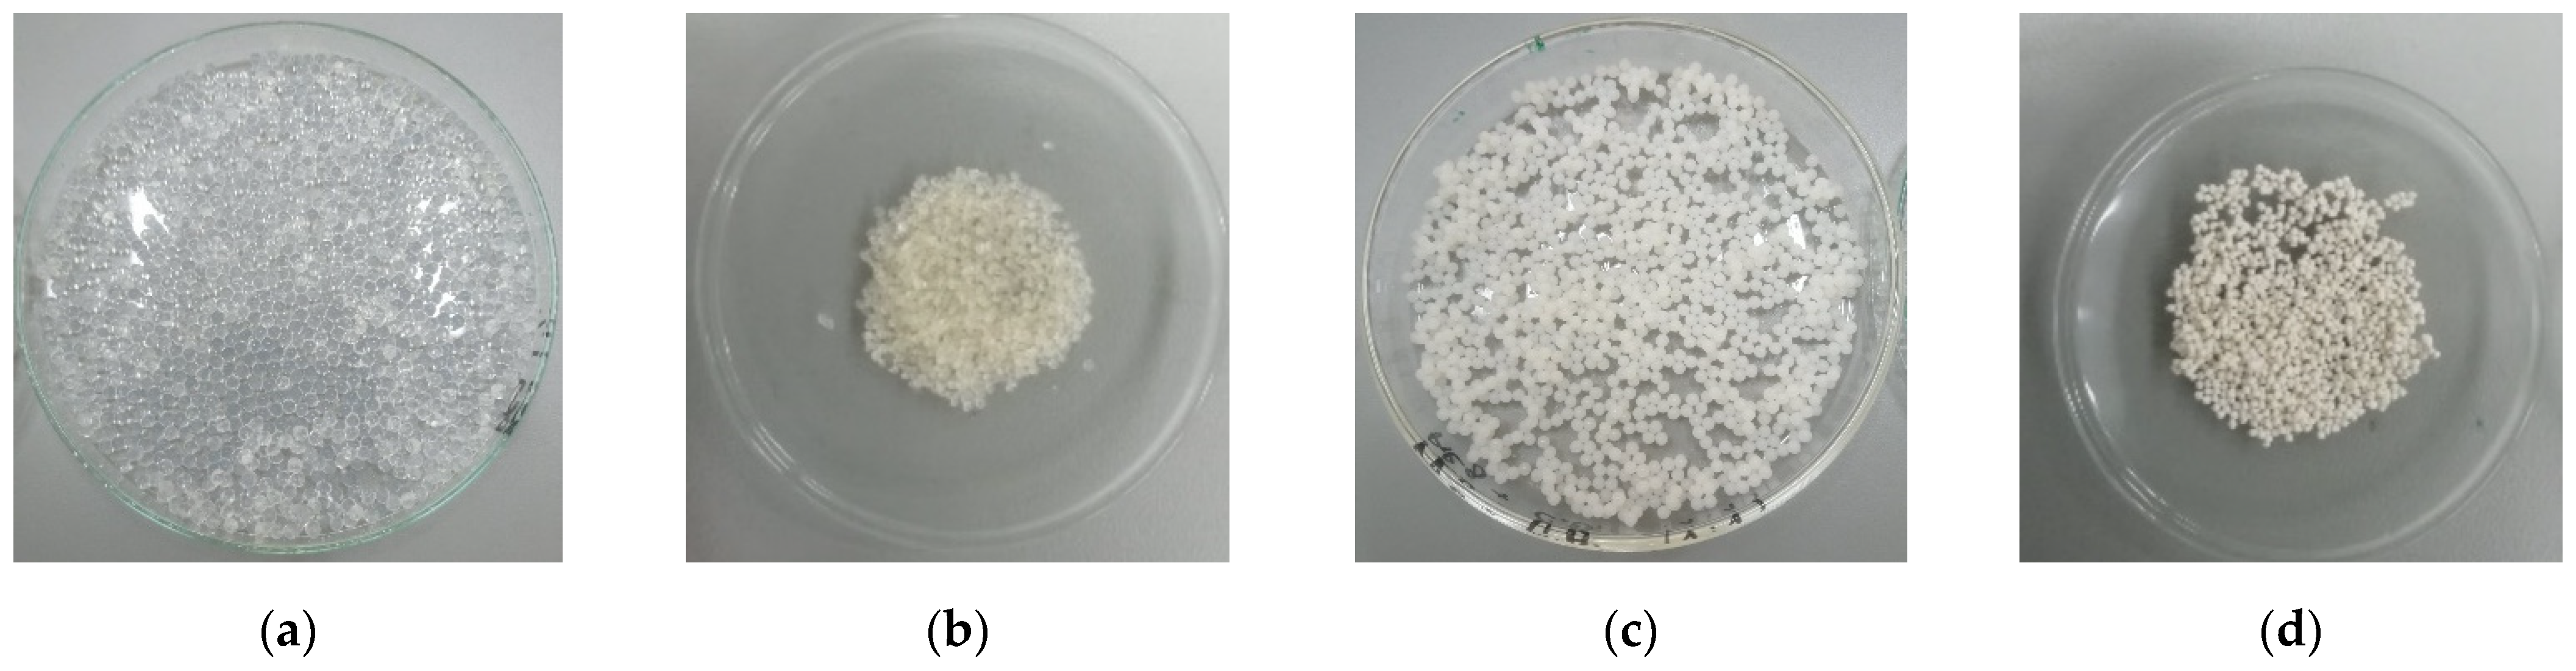
Materials 14 03946 g002 550

Novel Adsorbent Based on Banana Peel Waste for Removal of Heavy Metal Ions from Synthetic Solutions
Abstract
:1. Introduction
2. Materials and Methods
2.1. Chemicals and Reagents
2.2. Preparation of the Banana Peel Ash (BPA)
2.3. Preparation of the Alginate Microbeads
2.4. Preparation of the Chitosan Microbeads
2.5. Characterization of the Microbeads
2.6. Removal Efficiency Testing of the Materials
3. Results and Discussion
3.1. ATR-FTIR Analysis
3.1.1. BPA
3.1.2. ALG and ALG–BPA Microbeads
3.1.3. CS and CS–BPA Microbeads
3.2. Optical Microscopy Analysis
3.2.1. ALG and ALG–BPA Microbeads
3.2.2. CS and CS–BPA (1:1) Micro Beads
3.3. SEM-EDS Analysis
3.3.1. BPA
3.3.2. ALG and ALG–BPA Microbeads
3.3.3. CS and CS–BPA Microbeads
3.4. Batch Adsorption Tests
3.4.1. Testing of the BPA
3.4.2. Testing the Polysaccharide-BPA Materials
4. Conclusions
Author Contributions
Funding
Institutional Review Board Statement
Informed Consent Statement
Data Availability Statement
Conflicts of Interest
References
- Reichel, A.; De Schoenmakere, M.; Jeroen, G. Circular Economy in Europe: Developing the Knowledge Base; European Environment Agency: Copenhagen, Denmark, 2016. [Google Scholar]
- Esparza, I.; Jiménez-Moreno, N.; Bimbela, F.; Azpilicueta, C.A.; Gandía, L.M. Fruit and vegetable waste management: Conventional and emerging approaches. J. Environ. Manag. 2020, 265, 110510. [Google Scholar] [CrossRef] [PubMed]
- Vakili, M.; Rafatullah, M.; Salamatinia, B.; Abdullah, A.Z.; Ibrahim, M.H.; Tan, K.B.; Gholami, Z.; Amouzgar, P. Application of chitosan and its derivatives as adsorbents for dye removal from water and wastewater: A review. Carbohydr. Polym. 2014, 113, 115–130. [Google Scholar] [CrossRef]
- Zia, Z.; Hartland, A.; Mucalo, M.R. Use of low-cost biopolymers and biopolymeric composite systems for heavy metal removal from water. Int. J. Environ. Sci. Technol. 2020, 17, 1–18. [Google Scholar] [CrossRef]
- Masindi, V.; Muedi, K. Environmental Contamination by Heavy Metals. In Heavy Metals; Saleh, H.M., Aglan, R., Eds.; IntechOpen: London, UK, 2018. [Google Scholar]
- Queiroz, L.S.; de Souza, L.K.; Thomaz, K.T.C.; Lima, E.T.L.; Filho, G.N.D.R.; Nascimento, L.D.; Pires, L.H.D.O.; Faial, K.D.C.F.; da Costa, C.E. Activated carbon obtained from amazonian biomass tailings (acai seed): Modification, characterization, and use for removal of metal ions from water. J. Environ. Manag. 2020, 270, 110868. [Google Scholar] [CrossRef]
- Yao, S.; Zhang, J.; Shen, D.; Xiao, R.; Gu, S.; Zhao, M.; Liang, J. Removal of Pb(II) from water by the activated carbon modified by nitric acid under microwave heating. J. Colloid Interface Sci. 2016, 463, 118–127. [Google Scholar] [CrossRef]
- Zainol, Z.; Nicol, M. Ion-exchange equilibria of Ni2+, Co2+, Mn2+ and Mg2+ with iminodiacetic acid chelating resin Amberlite IRC 748. Hydrometallurgy 2009, 99, 175–180. [Google Scholar] [CrossRef] [Green Version]
- Abbasi, P.; McKevitt, B.; Dreisinger, D.B. The kinetics of nickel recovery from ferrous containing solutions using an Iminodiacetic acid ion exchange resin. Hydrometallurgy 2018, 175, 333–339. [Google Scholar] [CrossRef]
- Nleya, Y.; Simate, G.S.; Ndlovu, S. Sustainability assessment of the recovery and utilisation of acid from acid mine drainage. J. Clean. Prod. 2016, 113, 17–27. [Google Scholar] [CrossRef]
- Acharya, B.S.; Kharel, G. Acid mine drainage from coal mining in the United States—An overview. J. Hydrol. 2020, 588, 125061. [Google Scholar] [CrossRef]
- Khademian, E.; Salehi, E.; Sanaeepur, H.; Galiano, F.; Figoli, A. A systematic review on carbohydrate biopolymers for adsorptive remediation of copper ions from aqueous environments part A: Classification and modification strategies. Sci. Total Environ. 2020, 738, 139829. [Google Scholar] [CrossRef] [PubMed]
- Daraei, P.; Madaeni, S.S.; Salehi, E.; Ghaemi, N.; Ghari, H.S.; Khadivi, M.A.; Rostami, E. Novel thin film composite membrane fabricated by mixed matrix nanoclay/chitosan on PVDF microfiltration support: Preparation, characterization and performance in dye removal. J. Membr. Sci. 2013, 436, 97–108. [Google Scholar] [CrossRef]
- Salehi, E.; Daraei, P.; Shamsabadi, A.A. A review on chitosan-based adsorptive membranes. Carbohydr. Polym. 2016, 152, 419–432. [Google Scholar] [CrossRef]
- Algothmi, W.M.; Bandaru, N.M.; Yu, Y.; Shapter, J.; Ellis, A. Alginate–graphene oxide hybrid gel beads: An efficient copper adsorbent material. J. Colloid Interface Sci. 2013, 397, 32–38. [Google Scholar] [CrossRef]
- Yu, K.; Ho, J.; McCandlish, E.; Buckley, B.; Patel, R.; Li, Z.; Shapley, N.C. Copper ion adsorption by chitosan nanoparticles and alginate microparticles for water purification applications. Colloids Surf. A Physicochem. Eng. Asp. 2013, 425, 31–41. [Google Scholar] [CrossRef]
- Kim, B.; Lim, S.-T. Removal of heavy metal ions from water by cross-linked carboxymethyl corn starch. Carbohydr. Polym. 1999, 39, 217–223. [Google Scholar] [CrossRef]
- Bhat, M.A.; Chisti, H.; Shah, S.A. Removal of Heavy Metal Ions from Water by Cross-Linked Potato Di-Starch Phosphate Polymer. Sep. Sci. Technol. 2015, 50, 1741–1747. [Google Scholar] [CrossRef]
- Güçlü, G.; Keleş, S.; Güçlü, K. Removal of Cu2+ Ions from Aqueous Solutions by Starch-Graft-Acrylic Acid Hydrogels. Polym. Technol. Eng. 2006, 45, 55–59. [Google Scholar] [CrossRef]
- Kosseva, M.R. Recent European Legislation on Management of Waste in the Food Industry. In Food Industry Waste; Elsevier: Amsterdam, The Netherlands, 2013; pp. 3–15. [Google Scholar]
- Na, Y.; Lee, J.; Lee, S.H.; Kumar, P.; Kim, J.H.; Patel, R. Removal of heavy metals by polysaccharide: A review. Polym. Technol. Mater. 2020, 59, 1770–1790. [Google Scholar] [CrossRef]
- Lagoa, R.; Rodrigues, J.R. Kinetic analysis of metal uptake by dry and gel alginate particles. Biochem. Eng. J. 2009, 46, 320–326. [Google Scholar] [CrossRef]
- Cataldo, S.; Gianguzza, A.; Milea, D.; Muratore, N.; Pettignano, A. Pb(II) adsorption by a novel activated carbon alginate composite material. A kinetic and equilibrium study. Int. J. Biol. Macromol. 2016, 92, 769–778. [Google Scholar] [CrossRef] [PubMed]
- DeMessie, B.; Sahle-Demessie, E.; Sorial, G.A. Cleaning Water Contaminated with Heavy Metal Ions Using Pyrolyzed Biochar Adsorbents. Sep. Sci. Technol. 2015, 50, 2448–2457. [Google Scholar] [CrossRef]
- Taskin, E.; Bueno, C.D.C.; Allegretta, I.; Terzano, R.; Rosa, A.H.; Loffredo, E. Multianalytical characterization of biochar and hydrochar produced from waste biomasses for environmental and agricultural applications. Chemosphere 2019, 233, 422–430. [Google Scholar] [CrossRef]
- Chawla, J.; Kumar, R.; Kaur, I. Carbon nanotubes and graphenes as adsorbents for adsorption of lead ions from water: A review. J. Water Supply Res. Technol. 2015, 64, 641–659. [Google Scholar] [CrossRef]
- Lee, B.R.; Lee, K.H.; Kang, E.; Kim, D.-S.; Lee, S.-H. Microfluidic wet spinning of chitosan-alginate microfibers and encapsulation of HepG2 cells in fibers. Biomicrofluidics 2011, 5, 022208. [Google Scholar] [CrossRef] [Green Version]
- Wang, W.; Zhao, Y.; Bai, H.; Zhang, T.; Ibarra-Galvan, V.; Song, S. Methylene blue removal from water using the hydrogel beads of poly(vinyl alcohol)-sodium alginate-chitosan-montmorillonite. Carbohydr. Polym. 2018, 198, 518–528. [Google Scholar] [CrossRef] [PubMed]
- Hashem, A.; Elhmmali, M.M. Modification of Sodium Alginate for the Removal of Cd(II) from Aqueous Solutions. Polym. Technol. Eng. 2006, 45, 707–712. [Google Scholar] [CrossRef]
- Rios-Donato, N.; Carrion, L.G.E.; Mayorga, J.A.R.; Verduzco-Navarro, I.P.; Katime, I.; Mendizabal, E. Removal of Cd (II) from aqueous solutions by batch and continuous process using chitosan sulfate dispersed in a calcium alginate hydrogel. Afinidad 2018, 75, 112–118. [Google Scholar]
- Nastaj, J.; Przewłocka, A.; Rajkowska-Myśliwiec, M. Biosorption of Ni(II), Pb(II) and Zn(II) on calcium alginate beads: Equilibrium, kinetic and mechanism studies. Pol. J. Chem. Technol. 2016, 18, 81–87. [Google Scholar] [CrossRef] [Green Version]
- Abou-Zeid, R.E.; Ali, K.A.; Gawad, R.M.A.; Kamal, K.H.; Kamel, S.; Khiari, R. Removal of Cu(II), Pb(II), Mg(II), and Fe(II) by Adsorption onto Alginate/Nanocellulose Beads as Bio-Sorbent. J. Renew. Mater. 2021, 9, 601–613. [Google Scholar] [CrossRef]
- Râpă, M.; Matei, E.; Turcanu, A.; Predescu, A.M.; Pantilimon, M.C.; Predescu, C. structural, morphological and thermal analysis of some alginate/starch/dellite hps composites for aqueous cu(ii) removal. Cellul. Chem. Technol. 2019, 53, 561–571. [Google Scholar] [CrossRef]
- Ngah, W.W.; Fatinathan, S. Adsorption of Cu(II) ions in aqueous solution using chitosan beads, chitosan–GLA beads and chitosan–alginate beads. Chem. Eng. J. 2008, 143, 62–72. [Google Scholar] [CrossRef]
- Zhao, F.; Repo, E.; Yin, D.; Sillanpää, M.E. Adsorption of Cd(II) and Pb(II) by a novel EGTA-modified chitosan material: Kinetics and isotherms. J. Colloid Interface Sci. 2013, 409, 174–182. [Google Scholar] [CrossRef]
- Matei, E.; Predescu, A.M.; Râpă, M.; Tarcea, C.; Pantilimon, C.M.; Favier, L.; Berbecaru, A.C.; Sohaciu, M.; Predescu, C. Removal of Chromium(VI) from Aqueous Solution Using a Novel Green Magnetic Nanoparticle—Chitosan Adsorbent. Anal. Lett. 2019, 52, 2416–2438. [Google Scholar] [CrossRef]
- Mosoarca, G.; Vancea, C.; Popa, S.; Boran, S.; Tanasie, C. A green approach for treatment of wastewater with manganese using wood ash. J. Chem. Technol. Biotechnol. 2020, 95, 1781–1789. [Google Scholar] [CrossRef]
- Pehlivan, E.; Kahraman, H. Sorption equilibrium of Cr(VI) ions on oak wood charcoal (Carbo Ligni) and charcoal ash as low-cost adsorbents. Fuel Process. Technol. 2011, 92, 65–70. [Google Scholar] [CrossRef]
- Bordoloi, S.; Nath, S.K.; Dutta, R.K. Iron ion removal from groundwater using banana ash, carbonates and bicarbonates of Na and K, and their mixtures. Desalination 2011, 281, 190–198. [Google Scholar] [CrossRef]
- Das, B.; Hazarika, P.; Saikia, G.; Kalita, H.; Goswami, D.C.; Das, H.B.; Dube, S.N.; Dutta, R.K. Removal of iron from groundwater by ash: A systematic study of a traditional method. J. Hazard. Mater. 2007, 141, 834–841. [Google Scholar] [CrossRef] [PubMed]
- Yang, K.; Gao, Q.; Tan, Y.; Tian, W.; Weiqian, T.; Zhu, L.; Yang, C. Biomass-Derived Porous Carbon with Micropores and Small Mesopores for High-Performance Lithium-Sulfur Batteries. Chem. A Eur. J. 2016, 22, 3239–3244. [Google Scholar] [CrossRef]
- Fungaro, D.A.; Da Silva, M.V. Utilization of Water Treatment Plant Sludge and Coal Fly Ash in Brick Manufacturing. Am. J. Environ. Prot. 2014, 2, 83–88. [Google Scholar] [CrossRef] [Green Version]
- Yahya, Z.; Abdullah, M.M.A.B.; Hussin, K.; Ismail, K.N.; Sandu, A.V.; Vizureanu, P.; Abd Razak, R. Chemical and Physical Characterization of Boiler Ash from Palm Oil Industry Waste for Geopolymer Composite. Rev. Chim. 2013, 64, 1408–1412. [Google Scholar]
- Daemi, H.; Barikani, M. Synthesis and characterization of calcium alginate nanoparticles, sodium homopolymannuronate salt and its calcium nanoparticles. Sci. Iran. 2012, 19, 2023–2028. [Google Scholar] [CrossRef] [Green Version]
- Vijaya, Y.; Popuri, S.R.; Boddu, V.M.; Krishnaiah, A. Modified chitosan and calcium alginate biopolymer sorbents for removal of nickel (II) through adsorption. Carbohydr. Polym. 2008, 72, 261–271. [Google Scholar] [CrossRef]

| ALG Microbeads | ALG–BPA (1:1) Microbeads | ||
|---|---|---|---|
| Peak At | Assigned | Peak At | Assigned |
| 814 | CH bending | 871 | CH bending |
| 1022 | C–O–C | 1007 | C–O–C |
| 1413 | carboxylate salt ion | 1418 | carboxylate salt ion |
| 1592 | 1595 | ||
| 2891 | –CH | 2910 | –CH |
| 3329 | –OH | 3342 | –OH |
| CS Microbeads | CS–BPA (1:1) Microbeads | ||
|---|---|---|---|
| Peak At | Assigned | Peak At | Assigned |
| 817 | CH bending | 1057 | C–O–C |
| 898 | CH bending | 1315 | C–N |
| 1029 | C–O–C | 1396 | CH3 bending |
| 1315 | C–N | 1550 | NH2 |
| 1391 | CH3 bending | 1640 | C=O |
| 1556 | NH2 | 2921 | C–H |
| 1641 | C=O | 3308 | –OH, NH2 |
| 2865 | CH stretching | – | – |
| 2929 | – | – | |
| 3357 | OH, NH2 | – | – |
Publisher’s Note: MDPI stays neutral with regard to jurisdictional claims in published maps and institutional affiliations. |
© 2021 by the authors. Licensee MDPI, Basel, Switzerland. This article is an open access article distributed under the terms and conditions of the Creative Commons Attribution (CC BY) license (https://creativecommons.org/licenses/by/4.0/).
Share and Cite
Negroiu, M.; Țurcanu, A.A.; Matei, E.; Râpă, M.; Covaliu, C.I.; Predescu, A.M.; Pantilimon, C.M.; Coman, G.; Predescu, C. Novel Adsorbent Based on Banana Peel Waste for Removal of Heavy Metal Ions from Synthetic Solutions. Materials 2021, 14, 3946. https://doi.org/10.3390/ma14143946
Negroiu M, Țurcanu AA, Matei E, Râpă M, Covaliu CI, Predescu AM, Pantilimon CM, Coman G, Predescu C. Novel Adsorbent Based on Banana Peel Waste for Removal of Heavy Metal Ions from Synthetic Solutions. Materials. 2021; 14(14):3946. https://doi.org/10.3390/ma14143946
Chicago/Turabian StyleNegroiu, Mihai, Anca Andreea Țurcanu, Ecaterina Matei, Maria Râpă, Cristina Ileana Covaliu, Andra Mihaela Predescu, Cristian Mircea Pantilimon, George Coman, and Cristian Predescu. 2021. "Novel Adsorbent Based on Banana Peel Waste for Removal of Heavy Metal Ions from Synthetic Solutions" Materials 14, no. 14: 3946. https://doi.org/10.3390/ma14143946
APA StyleNegroiu, M., Țurcanu, A. A., Matei, E., Râpă, M., Covaliu, C. I., Predescu, A. M., Pantilimon, C. M., Coman, G., & Predescu, C. (2021). Novel Adsorbent Based on Banana Peel Waste for Removal of Heavy Metal Ions from Synthetic Solutions. Materials, 14(14), 3946. https://doi.org/10.3390/ma14143946

